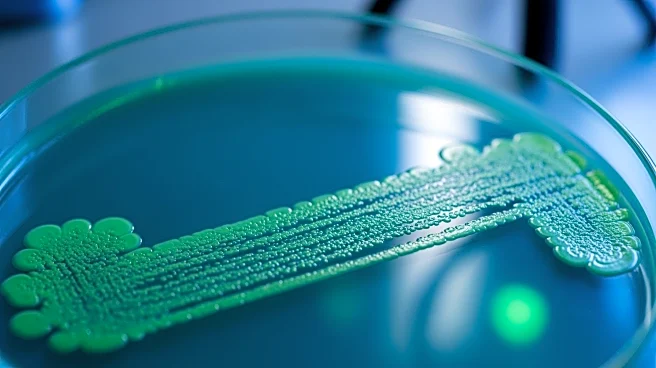
Scientists Warn of Rapidly Spreading Antibiotic-Resistant Typhoid Strains

What's Happening?
Recent research has highlighted the growing threat of extensively drug-resistant (XDR) typhoid fever, caused by the bacterium Salmonella enterica serovar Typhi. This bacterium is becoming increasingly
resistant to both traditional and newer antibiotics, posing a significant public health challenge. The study, which sequenced the genomes of thousands of S Typhi strains from South Asia, found that these resistant strains are spreading globally, with cases identified in the UK, US, and Canada. The rapid emergence and spread of these strains underscore the urgent need for expanded prevention measures, including the use of typhoid conjugate vaccines in endemic regions.
Why It's Important?
The rise of antibiotic-resistant typhoid strains is a major concern for global health, as it threatens the effectiveness of current treatment options. With the potential for these strains to spread internationally, there is an increased risk of outbreaks in regions previously considered low-risk. The situation highlights the critical need for global cooperation in expanding vaccine access and investing in new antibiotic research. Failure to address this issue could lead to a significant health crisis, as untreated typhoid can be fatal in a substantial percentage of cases.
What's Next?
To combat the spread of XDR typhoid, health experts are advocating for the rapid expansion of typhoid vaccination programs, particularly in high-risk areas. Countries like Pakistan have already begun routine immunization efforts, setting an example for others to follow. Additionally, ongoing research into new antibiotics and treatment strategies is essential to stay ahead of the evolving resistance patterns. The World Health Organization's prequalification of typhoid conjugate vaccines marks a step forward in prevention efforts, but widespread implementation is necessary to mitigate the threat.